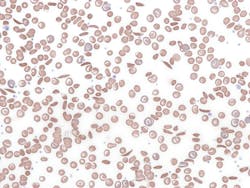
672a2cecc9dd02128ab5938c Dreamstime Xxl 319586066 672a2cecc9dd02128ab5938c Dreamstime Xxl 319586066
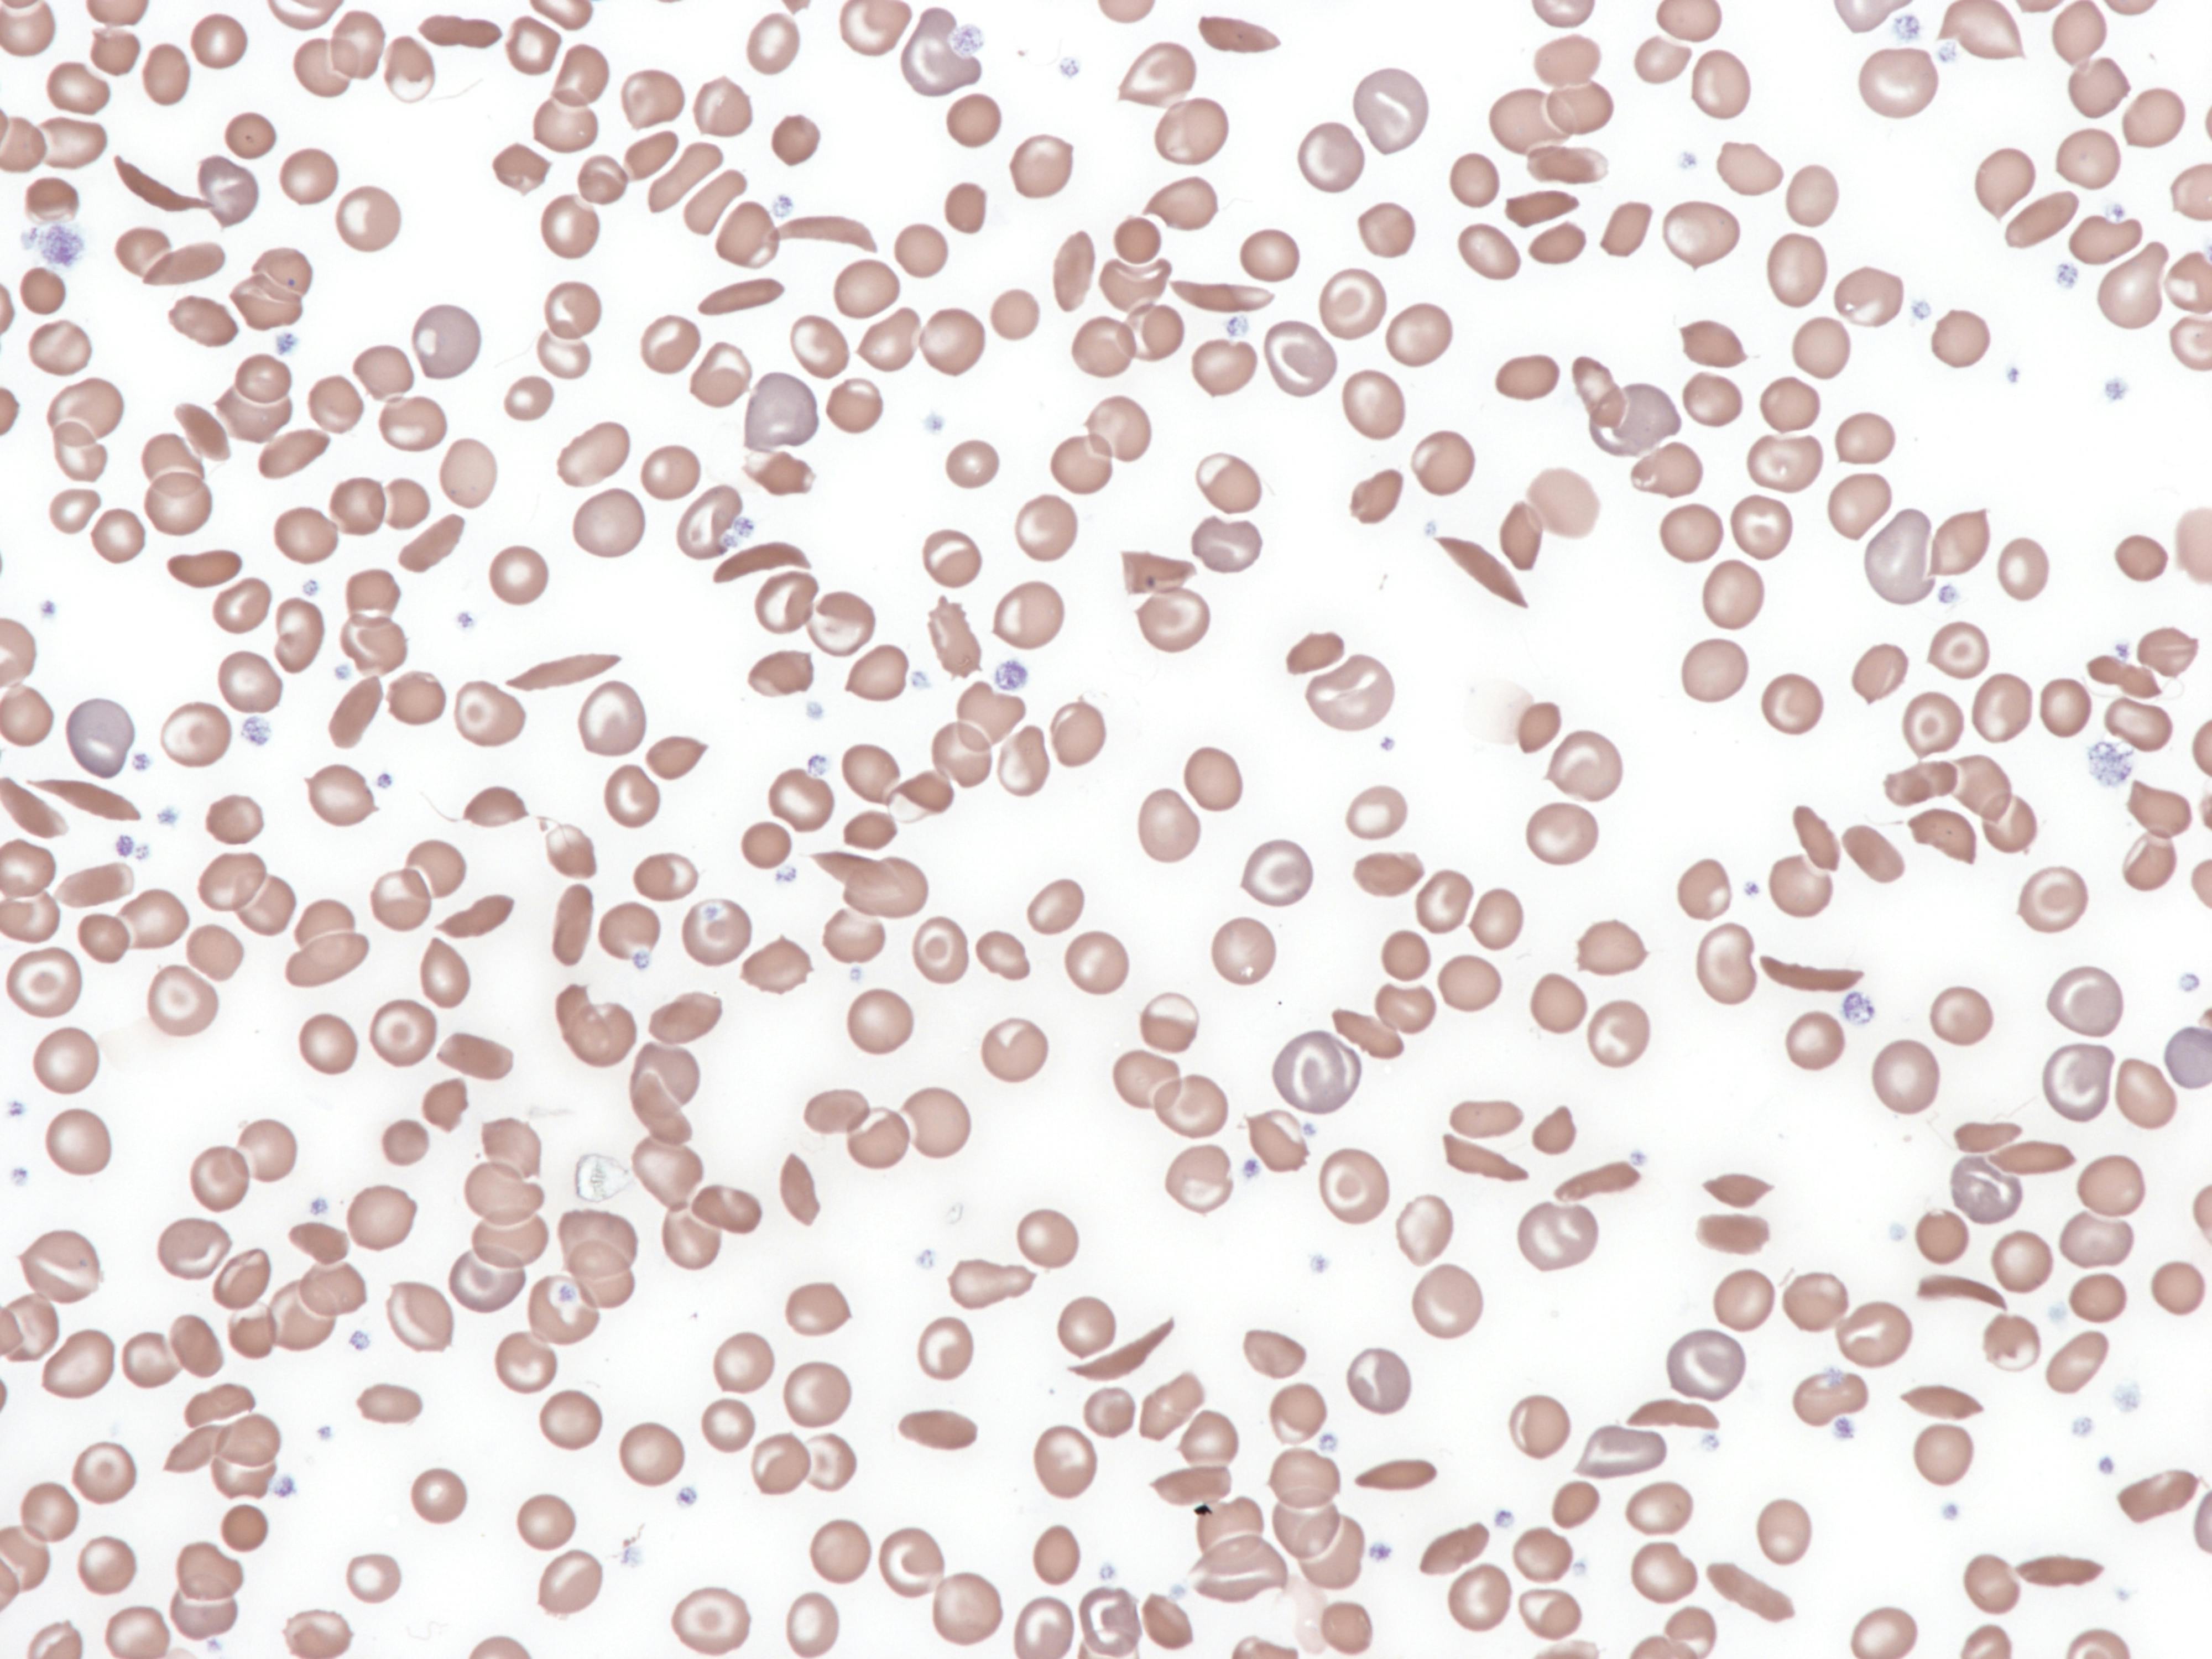
672a2cecc9dd02128ab5938c Dreamstime Xxl 319586066

The Centers for Medicare & Medicaid Services (CMS) released a Sickle Cell Disease (SCD) Provider Toolkit which focuses on strengthening the infrastructure across care settings to care for people with SCD, improving care management, and supporting the needs of people with SCD.
The toolkit includes information on how CMS program coverage can assist people with SCD and educational materials for individuals with SCD and other community partners who serve them.
About the Author
Sign up for our eNewsletters
Get the latest news and updates